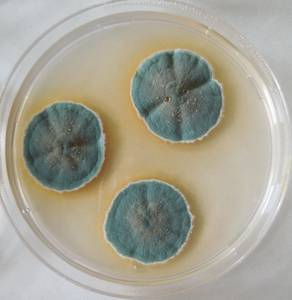
MSU_FS-03289_01, Район К Банг (K'Bang districts), Провинция Зялай (Gia Lai province) (Вьетнам)

Всего записей: 1
Всего страниц: 1
По организмам
- ID образца
- 0000001189770
- Вид
- Aspergillus sylvaticus
- Штамм
- MSU_FS-03289
- Место сбора
- Район К Банг (K'Bang districts), Провинция Зялай (Gia Lai province) (Вьетнам)
- Топоним
- Кронг (Kroong (K'Rong) commune)